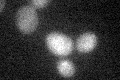
YBR040W
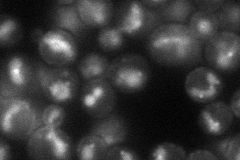
YBR040W

View description
Integral membrane protein required for efficient mating; may participate in or regulate the low affinity Ca2+ influx system, which affects intracellular signaling and cell-cell fusion during mating
Localization:
Intensity:
Fold change:
Significance:
-
C’ GFP library in SD
below threshold15.3 -
N' NOP1pr-GFP in SD
vacuole47.6342 -
N' TEF2pr-mCherry in SD

vacuole151.83 -
N' NATIVEpr-GFP in SD

below threshold17.6286 -
N' TEF2pr-VC and Cyto-VN in SD

below threshold24.5456 -
C’ GFP library in SD+DTT

cytosol14.760.96No -
C’ GFP library in SD+H2O2

cytosol14.210.92No -
C’ GFP library in Starvation Media

cytosol15.771.03No -
C’ GFP library on the background of Pup2-DaMP

below threshold -
C’ GFP library on the background of CCT mutant

below threshold15.58461.01764No
